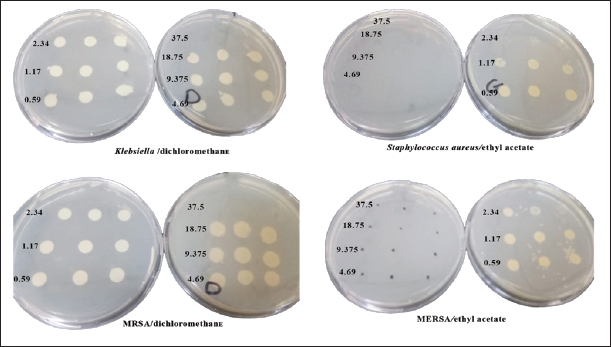

| Research Article | ||
Open Vet. J.. 2024; 14(4): 990-1001 Open Veterinary Journal, (2024), Vol. 14(4): 990–1001 Original Research Anti-MRSA and cytotoxic activities of different solvent extracts from Artemisia herba-alba grown in Shubak, JordanReham D. Alghonmeen1, Saif M. Dmour1, Sultan A.M. Saghir1*, Saqr Abushattal1, Sulaiman Alnaimat1, Mohammed Al-zharani2, Fahd A. Nasr2 and Osama Y. Althunibat11Department of Medical Analysis, Princess Aisha Bint Al-Hussein College of Nursing and Health Sciences, Al-Hussein Bin Talal University, Ma‘an, Jordan 2Biology Department, College of Science, Imam Mohammad Ibn Saud Islamic University (IMSIU), Riyadh, Saudi Arabia *Corresponding Author: Sultan A.M. Saghir. Department of Medical Analysis, Princess Aisha Bint Al-Hussein College of Nursing and Health Sciences, Al-Hussein Bin Talal University, Ma‘an, Jordan. Email: sultan.s.ayesh [at] ahu.edu.jo Submitted: 21/11/2023 Accepted: 03/03/2024 Published: 30/04/2024 © 2024 Open Veterinary Journal
AbstractBackground: Globally, resistance to antimicrobial drugs is a major hazard to public health. Infections that were once easily treatable with antibiotics are becoming harder to control, leading to prolonged illnesses, increased mortality rates, and higher healthcare costs. Aim: This study intended to assess the antimicrobial, specifically the anti-Methicillin resistant Staphylococcus aureus (MRSA), and anticancer properties of different extracts obtained from A. herba-alba (AHA). Methods: The antibacterial tests of AHA were performed on two Gram-negative bacterial strains (Escherichia coli and Klebsiella pneumonia), two Gram-positive bacterial strains (Methicillin-resistant Staphylococcus aureus (MRSA), and Staphylococcus aureus). Initial screening for antibacterial activities was conducted using the well diffusion technique. Subsequently, the minimum inhibitory concentration (MIC) and minimum bactericidal concentration (MBC) were determined through the broth-dilution assay. The anticancer test was carried out in vitro on a human colorectal carcinoma cell line (HCT-116) using MTT assay. Results: Among all extracts, n-hexane extract of AHA was the most effective against S. aureus with the highest inhibition zone (24.67 mm ± 0.58) compared to standard antibiotic (erythromycin, 24.00 mm) followed by the methanolic extract against MRSA (24.00 mm ± 1.73). The methanol extract of AHA showed the highest antibacterial activity against MRSA. The results of MIC and MBC of the AHA methanol extract against MRSA were 1.17 ± 1.09 and 9.375 ± 0.0 mg/ml, respectively, demonstrating therapeutically significant antibacterial activity. Ethyl acetate extract has no antibacterial activity against E. coli and K. pneumonia. The findings indicated that the methanol extract of AHA exhibited the highest efficacy against the colorectal carcinoma cell line (HCT-116), with an IC50 value of 126.61 ± 13.35 μg/ml. Conclusion: These findings suggest that the methanol extract of AHA could be considered as a potential agent to serve as a source of antibacterial and anticancer compounds. Keywords: A. herba-alba, Antimicrobial activity, Cytotoxicity, Solvent extracts. IntroductionSeveral critical illnesses are brought on by multidrug-resistant strains of pathogens such as Enterococcus faecium, Staphylococcus aureus, Klebsiella pneumoniae, Acinetobacter baumannii, and Pseudomonas aeruginosa (Harding et al., 2018; Hwang and Yoon, 2019; Lasko and Nicolau, 2020). Antibiotic-resistant bacteria (ARB) strains can cause various infections, such as gastritis, food poisoning, urinary tract infections, and encephalitis (Caneiras et al., 2019; Huang et al., 2022). Due to the current constraints in treating these conditions with available medications, it is anticipated that they will surpass cancer as the primary cause of death by the year 2050. This is because conventional antibiotics may not effectively combat infections caused by ARB (Murray et al., 2022). Antimicrobial resistance (AMR) has been recognized as an important threat to public health systems worldwide, not just in developing countries. Drug-resistant microbial infections cause 23,000 deaths worldwide every year, including in developed countries like the United States. Similar facts exist in Europe, but they are much greater in developing countries of Asia, such as India, Latin America, and Africa (Davis et al., 2017). Antibiotics can no longer be used to treat infectious infections, signaling an uncertain future for healthcare. AMR infection causes significant diseases, long-term hospital stays, greater healthcare expenses, higher second-line drug costs, and treatment failures (Thorpe et al., 2018). For example, it has been estimated that antibiotic resistance costs more than nine billion euros annually only in Europe (Dixit et al., 2019). In addition, the Centers for Disease Control and Prevention estimates that antibiotic resistance raises direct healthcare expenditures in the United States by an additional $20 billion annually, not including the estimated $35 billion in productivity losses (Dadgostar, 2019). Due to a diminishing in antimicrobial discovery by the major pharmaceutical companies, the development of new antibiotics has been reducing quickly over the past few decades. Finding new alternatives, such as those derived from medicinal plants, is therefore interesting. Beneficial phytochemicals found in medicinal plants can be utilized in the prevention of disease and treatment of various ailments across the globe (Aanouz et al., 2021). In addition, around three quarters (80%) of the Arab population uses herbal medicine for treatment and prevention (El-Dahiyat et al., 2020). Over the past few decades, medicinal plants have garnered significant attention in pharmacological research owing to their substantial content of polyphenols, quinines, flavonoids, and alkaloids (Adu-Amankwaah et al., 2023). The bioactive compounds in these plants generally have anti-inflammatory (Živković et al., 2020), cardioprotective, anti-carcinogenic (Mbuni et al., 2020), antioxidant (Kaçar et al., 2022), antiseptic, antibacterial, and antifungal properties (Elsonbaty et al., 2020). Jordan’s diverse geography and climate contribute to the presence of a wide variety of wild plants across the country (Al-Qura’n, 2009). There are approximately 868 genera and 142 families of plant species. There are 2,543 species of medicinal plants, and they are widely distributed over the country (Basheti et al., 2017). Artemisia herba-alba (AHA) (“desert wormwood” in English; “sheeh” in Arabic) is a medicinal and highly aromatic dwarf shrub that is typical of the steppes and deserts of North Africa (Tunisia, Algeria, and Morocco), Middle East (Egypt and Jordan), Southern Europe (Spain), and extends into the Northwestern Himalaya. AHA plant extract has long been utilized extensively in different countries in traditional medicine as soup or tea for the treatment of a variety of illnesses such as colds, coughing, intestinal disturbances, bronchitis, diarrhea, neuralgias arterial hypertension, reduces blood glucose levels (Wazaify et al., 2011), and inflammations caused by fungal, bacterial, or viral infections (Jouad et al., 2001; Laid et al., 2008; Abu-Darwish et al., 2015; Ouguirti et al., 2021).
Fig. 1. Image of AHA plant from Shubak City (Jordan). AHA belongs to the family Asteraceae, which comprises about 1,600 genera and more than 25,000 species (Nikolić and Stevović, 2015). The 20–50 cm tall, green perennial shrub AHA has tiny, hairy leaves. Although flowering occurs in September and lasts until December, the complete growth starts at the end of the summer with a fuzzy hair stem (Fig. 1) (Moufid and Eddouks, 2012). Due to its diverse pharmacological and biological properties, AHA exhibits various beneficial effects, including its potential in antidiabetic (Bourebaba et al., 2023), antimicrobial (Dif and Fatima Zohra, 2023), antitumor (Mohammed et al., 2019), antimalarial, antioxidant (Mohammed et al., 2021), insecticidal, and neurological activities (Boukraa et al., 2022). This study aims to examine the antibacterial properties of various extracts (including n-hexane, dichloromethane, ethyl acetate, and methanol) from AHA, focusing on their effectiveness against Methicillin-resistant Staphylococcus aureus (MRSA) as well as various types of both Gram-positive and Gram-negative bacteria. Furthermore, the study will assess their anticancer potential against colorectal carcinoma cell line (HCT-116). Materials and MethodsChemicals and reagentsAll chemicals and reagents used were of analytical grade. Dichloromethane, ethyl acetate, methanol, and n-hexane, Mueller Hinton Broth (MHB), nutrient agar, dimethyl sulfoxide (DMSO), erythromycin, and cefotaxime were purchased from Merck (Mumbai, India) and Sigma-Aldrich (St. Louis, MO). Collection and identification of plant materialFresh plant AHA was harvested in the Shubak region of southern Jordan between March and April 2023. The herbarium specimen was verified by Professor Saleh Alquran (MU202309) from the Department of Biology, Faculty of Science, at Mutah University in Karak, Jordan. Sample extractionThe procedure of extraction was carried out according to Ogbiko et al. (2018). The whole plant of AHA was rinsed with running water, dried under shade for 72 hours, and pulverized electric blender into powder form. A Soxhlet extractor was used to extract the dried whole plant of AHA (50 g) using n-hexane, dichloromethane, ethyl acetate, and methanol as the solvents with growing polarity (each 500 ml). The obtained extracts were then dried using a rotary evaporator and kept for further analysis at 4°C in sealed glass containers. The extract was prepared at concentrations of 6% by dissolving in 10% DMSO (Stock solution=60 mg extract/1,000 μl of 10% DMSO). For determination of plant extract yield (% Yield), the dried extracts’ yield percentage (w/w) was estimated using the following formula: Yield (%)=A1 × 100/A2 where A1 is the dry weight of the extract after solvent evaporation and A2 is the weight of the dried whole plant powder. Antibacterial activity of different solvents extracts of AHABacterial isolates In this study, the antibacterial of AHA extract was investigated against Escherichia coli (E. coli) American Type Culture Collection (ATCC 25922), K. pneumonia ATCC 200603, S. aureus ATCC 29213, and one clinical isolate: MRSA, OQ568766, was provided by the Jordan University Hospital, Amman, Jordan. The strains included both Gram-negative as well as Gram-positive strains; for the antibacterial screening assay, all strains were initially sub-cultured in nutrient agar media and incubated at 37°C for 18 ± 2 hours. Antibacterial screeningAgar well diffusion method The antibacterial activity of methanol, ethyl acetate, dichloromethane, and n-hexane extracts was performed using the Agar well diffusion method according to the method of Bauer et al. (1966). Briefly, using a sterile swab, 100 μl of each test bacteria inoculated on Muller Hilton Agar was equivalent to a 0.5 McFarland standard. The wells were created using a sterilized cork borer (6 mm in diameter) into agar plates containing inoculums after 10 minutes of inoculation. After 24 hours of incubation at 37°C, the inhibitory zones (mm) were measured and the findings were compared to erythromycin (1.0 mg/disc). DMSO was employed as the negative control. The experiment was triplicate and the average values were calculated. Determination of minimum inhibitory concentrationThe minimum inhibitory concentration (MIC) and minimum bactericidal concentration (MBC) values of various extracts of AHA were assessed using the broth dilution method as outlined previously with certain modifications (Mushore and Matuvhunye, 2013). The assays were conducted on 96-well microtiter plates under aseptic conditions. For MIC evaluation in MHB, the extract working solution was serially diluted throughout the 96 wells to obtain final testing concentrations of 37.50, 18.75, 9.375, 4.69, 2.34, and 1.17 mg/ml with an optimum concentration of bacterial strains (108 CFU/ml) using 0.5 McFarland standard. In brief, all wells of the plate were filled with 90 μl of MHB, then the first column of the microtiter plate was filled with 100 μl of each solvent extract (100 mg/ml extract stock solution). A two-fold serial dilution was achieved by transferring 100 μl of diluents from the first column to the succeeding wells of each row. About 10 μl of bacterial suspension was added into each well, except for well 12. Each plate had a set of two controls: (a) positive control (11th wells) included test organisms only without test extract and (b) negative control (12 th wells) included only plant extract. The 96-well plates were incubated for 24 hours at 37°C in a temperature-controlled incubator. Values of MBC were determined by culturing wells’ content with concentrations higher than or equal to MIC on agar plates. MBC is defined as the lowest concentration of extracts or antimicrobial agents that kills tested bacteria (no growth in the agar plate) after 24 hours at 37°C. The MBC values were determined by subculturing 15 μl of a microtitre plate on sterile nutrient agar plates. The growth of bacteria was measured after 24 hours of incubation at 37°C. The MBC was carried out in triplicates. In vitro cytotoxicity evaluationCell culture and materials The colorectal carcinoma cell line (HCT-116) purchased from the ATCC was used for the cytotoxic assay. These cells were cultured in minimum essential medium supplemented with 10% FBS, 100 units/ml of penicillin, 100 mg/ml of streptomycin, and 2 mM L-glutamine. The cultures were maintained in a controlled environment with a 5% CO2 atmosphere at 37°C and subculture every 2 weeks. (3- [4,5-dimethylthiazol-2-yl]-2,5-diphenyl tetrazolium bromide (MTT) assay for cell viabilityThe cytotoxicity of the plant extract was established using (3- [4,5-dimethylthiazol-2-yl]-2,5-diphenyl tetrazolium bromide (MTT) assay. The cells were exposed to varying concentrations of plant extracts (31.25, 62.5, 125, 250, 500, and 1,000 μg/ml) and allowed to incubate for 48 hours. After the incubation period, test samples were extracted from the wells and replaced with 200 μl of fresh medium. Subsequently, 20 μl of MTT solution (5 mg/ml in PBS) was added and incubated for 4 hours. At the end of the incubation period, the medium in each well was aspirated, and the formazan crystals that had formed were dissolved by adding 50 μl of DMSO to each well on the plates. The plates were gently agitated until the crystals were fully dissolved. The degree of MTT reduction was promptly determined by measuring the absorbance at 570 nm (Mosmann, 1983). The human umbilical vein endothelial cells (HUVECs) cell line was used as a normal cell line to assess the selectivity of extracts against these different cell lines. The cell viability percentage was calculated using the following formula: % Cell viability=(A – B)/(C – B) × 100% where: A=absorbance of the test extract, B=blank absorbance, C=absorbance of the control. The IC50 values, which signify the concentration at which 50% of the cells were eradicated, were derived through the examination of linear regression plots. These graphical representations illustrated the concentration of the test sample necessary to achieve a 50% reduction in absorbance in comparison to untreated cells. Ethical approvalNot needed as this study does not involve experiments on animals or humans. ResultsEffects of various solvents on extraction yieldThe impact of different polarity solvents including nonpolar (n-hexane), medium-polar (ethyl acetate and dichloromethane), and polar (methanol) on the AHA extraction rate was studied and the results are shown in Figure 2. About 50 g of AHA powder was extracted by a Soxhlet extractor and concentrated using a rotary evaporator. The final weights of the AHA extracts were 6.982, 3.945, 3.105, and 0.685 g for methanol, dichloromethane, ethyl acetate, and n-hexane extract, respectively. The results indicated that the methanol extract of AHA had the highest yield at 13.96%, followed by the dichloromethane extract at 7.87%, and the ethyl acetate extract at 6.21%. Conversely, the n-hexane extract had the lowest yield, which was 1.37%. Hence, the variation in extraction yields can be attributed to the differing polarities of the various compounds present in AHA.
Fig. 2. Yield percentage of different solvents extract of AHA. Antibacterial activity of different solvents extracts of AHAAgar well diffusion assay The antimicrobial efficacy of different extracts (n-hexane, methanol, dichloromethane, and ethyl acetate) derived from the whole parts of AHA was assessed based on the zone of inhibition against a range of pathogens. The results (zone of inhibition) were then compared to the activity of erythromycin (1.0 mg/disc). The detailed findings concerning antimicrobial activity are presented in Table 1. The results of the present study clearly illustrate that erythromycin possesses a significant inhibitory effect against Gram-positive bacteria, including MRSA and S. aureus, with inhibition zones measuring 24 ± 0.00 and 34 ± 0.00 mm, respectively. These findings demonstrate that the crude n-hexane and dichloromethane extracts of AHA exhibit strong antimicrobial activity against all the examined microorganisms. In addition, all the extracts demonstrate potent antimicrobial activity against MRSA and S. aureus. In this study, various extracts from AHA showed significant inhibitory effects against all bacterial isolates tested, except for K. pneumonia and E. coli. These two strains displayed resistance to the ethyl acetate extract and erythromycin, while E. coli also exhibited resistance to the methanol extract. The n-hexane and dichloromethane extracts of AHA demonstrated inhibitory effects against MRSA, S. aureus, K. pneumonia, and E. coli. In contrast, the methanol extract of AHA exhibited effectiveness against MRSA, S. aureus, and K. pneumonia, while the ethyl acetate extract of AHA was effective solely against Gram-positive strains, namely MRSA and S. aureus. Table 1. Antimicrobial activity of AHA extracts against selected strains of Gram positive and Gram negative bacteria.
In n-hexane extract, the maximum inhibition zone diameter was observed in S. aureus with a diameter of 24.67 ± 0.58 mm. Similarly, methanol extract showed a maximum inhibition zone with a diameter of 24.00 ± 1.73 mm in MRSA and 22.67.4 ± 1.15 mm in S. aureus. The rank of antibacterial activity of hexane extract against each bacterial strain is: S. aureus > MRSA > E.coli > K. pneumonia. The dichloromethane extract of AHA showed considerable activity. Its activity against each strain is ranked according to MRSA > S. aureus > E. coli > K. pneumonia. The antimicrobial activity assayed for AHA extracts showed an overall inhibitory effect against MRSA (24.00 ± 1.73 mm) with the methanol extract, 22.67 ± 2.52 mm with the dichloromethane extract, and 21.00 ± 1.00 mm with the ethyl acetate extract, comparing with erythromycin (24 ± 0.00 mm) as a positive control. High activity against S. aureus was found with n-hexane and methanol extracts (24.67 ± 0.58 and 22.67 ± 1.15 mm, respectively) (Table 1). Determination of MICTable 2 demonstrates significant antibacterial activities of promising n-hexane, methanol, ethyl acetate, and dichloromethane crude extracts of AHA against test microorganisms reported as MIC. MIC is the term for the highest dilution or lowest concentration of extracts known to inhibit bacterial growth. The MIC values of the n-hexane extract ranged from 2.34 mg/ml (MRSA) to 4.69 mg/ml (S. aureus, K. pneumoniae, and E. coli) and the methanol extract ranged from 1.17 mg/ml (MRSA) to 37.5 mg/ml (S. aureus and K. pneumoniae). Also, the MIC values of the ethyl acetate extract ranged from 2.34 (MRSA) to 9.375 mg/ml (S. aureus and K. pneumoniae), and for the dichloromethane ranged from 4.69 (MRSA) to 9.375 mg/ml (S. aureus, K. pneumonia, and E. coli) (Table 2). Methanol extract of AHA also demonstrated the highest antibacterial activity, and therefore highest antimicrobial activities, against clinical MRSA with MIC of 1.17 mg/ml, and a comparatively highest MIC value was observed for S. aureus and K. pneumoniae (MIC of 37.5 mg/ml). Moreover, the ethyl acetate extract showed a MIC of 2.34 mg/ml against MRSA, and the dichloromethane extract showed a MIC of 9.375 mg/ml against all strains of microorganisms except MRSA (MIC of 4.69 mg/ml). These results demonstrate that the highest MIC (lowest antimicrobial activity) occurs when methanol is used as the solvent for extraction. Based on the MIC values of the selected bacteria, the highest MIC (37.5 mg/ml) was found in the presence of methanol extract against S. aureus and K. pneumonia. On the contrary, the lowest MIC values were observed when methanol extract was tested with MRSA. On the other hand, all four solvent extracts (methanol, n-hexane, ethyl acetate, and dichloromethane) are potent antimicrobials against MRSA with the lowest MIC values, 1.17, 2.34, 2.34, and 4.69 mg/ml, respectively (Table 2). Determination of MBCThe MBC is the lowest concentration of the several solvent extracts of AHA that kill 99.99% of bacteria. As shown in Table 2, the n-hexane extract showed antibacterial activity with MBC values ranging from 9.375 to 75 mg/ml. The MBC values for n-hexane extract were S. aureus=E. coli < MRSA < K. pneumonia. While the methanol extract showed antibacterial activity with MBC values ranging from 9.375 to 75 mg/ml. The MBC values for methanol extract were in MRSA < E. coli < K. pneumonia=S. aureus. Furthermore, ethyl acetate extract exhibited antibacterial activity with MBC values of 4.69–37.52 mg/ml. The MBC values of ethyl acetate extract were in MRSA ≤ S. aureus =E. coli < K. pneumonia. In contrast, the results revealed the antibacterial activity of dichloromethane extract with MBC values ranging from 18.75 to 37.51 mg/ml. The MBC values of dichloromethane extract were in S. aureus=E.coli ≤ MRSA=K. pneumonia. Figures 3 and 4 provide visual representations of selected examples illustrating the MIC determined through the gel diffusion method and the MBC of various extracts tested against different bacterial strains. Table 2. MIC and MBC values of different solvent extracts of AHA against the tested microorganisms (mg/ml).
Fig. 3. Well diffusion of different extracts on different types of bacteria. Cytotoxicity of the plant extracts against HTC-116 and HUVEC cell linesThe MTT assay was used to assess the cytotoxic effects of different AHA extracts against a colorectal carcinoma cell line (HCT-116) in comparison to the HUVEC cell line. As depicted in Figure 5, it is evident that all extracts exhibit potential anticancer activity in a dose-dependent manner following a 48-hour treatment, the results are expressed as % inhibition. Table 3 illustrates the results of cytotoxic effects (IC50) of different extracts on HCT-116 and HUVEC cell lines. It displayed notable variations among the examined extracts, with the methanol fraction showing the highest effect (IC50=126.61 ± 13.35 μg/ml), followed by the ethyl acetate extract (IC50=259.83 ± 9.55 μg/ml), the dichloromethane extract (IC50=266.07 ± 1.61 μg/ml), and finally, the n-hexane extract (IC50=351.55 ± 8.39 μg/ml) compared with HUVEC cell line. DiscussionThe reports from the World Health Organization highlighting the growing prevalence of antibiotic-resistant bacteria have intensified the exploration of plant extracts with antibacterial properties for therapeutic purposes (Kebede et al., 2021). As a member of the Asteraceae family, Artemisia is among several genera known for its richness in secondary metabolites and essential oils, which possess valuable therapeutic applications. In this aspect, AHA extracts have been shown a broad antibacterial action (Daoudi et al., 2022; Ouchelli et al., 2022). The choice of an appropriate solvent is a critical step in the extraction of natural resources. Therefore, this study focused on evaluating both the extraction yield and the antibacterial efficacy of AHA using different organic solvents, including n-hexane, methanol, dichloromethane, and ethyl acetate. The extraction yield differs depending on the choice of solvents. These variations in extraction yields can be attributed to the differing polarities of the solvents used. In the realm of phytochemical extraction techniques, methanol stands out as the most polar solvent commonly utilized. In the literature, it is often recommended to maximize the extraction of bioactive components from plants (Seo et al., 2014). The results showed that methanol, being the most polar solvent, yielded a higher extraction quantity compared to n-hexane, which is less polar in nature. On the other hand, the results suggest that AHA contains substances with higher polarity than the others, which aligns with the findings of Benmeziane et al. (2023), who noted that the extraction rate is influenced by the polarity of solvents. Benmeziane et al. (2023) reported that the AHA methanol extract yields approximately 12.2%, while the ethyl acetate extract yields around 4.5%. In contrast, the present study demonstrated relatively higher yields, with methanol extract at 13.96% and ethyl acetate extract at 6.21%.
Fig. 4. MBC of different extracts on different types of bacteria.
Fig. 5. Cytotoxic effect of different AHA extracts against HCT-116 cell line. M=methanol extract, E=ethyl acetate extract, D=dichloromethane, H=n-hexane extract. All values are expressed as mean ± SD, n=3. Table 3. Cytotoxic effects of different extracts on HCT-116 and normal cell line (HUVEC).
Clearly, the n-hexane extract displayed notable efficacy against all the tested microorganisms, particularly showing strong inhibitory effects against the S. aureus strain, with an impressive inhibition zone diameter of 24.67 mm. Moreover, the findings revealed that all extracts exhibited antimicrobial activity against the MRSA strains. Among these extracts, the methanol extract demonstrated the most significant inhibition zones, measuring 24 mm, a result comparable to the effectiveness of erythromycin. Furthermore, the results revealed that all extracts exhibited activity against the MRSA strains, with the highest level of activity observed in the methanol extracts. This particular extract demonstrated the most substantial inhibition zones, measuring 24 mm, a level of effectiveness comparable to that of erythromycin. These findings are consistent with the outcomes of previous studies conducted by Khan et al. (2022), who also reported that n-hexane and methanol solvent extracts exhibited the most potent antimicrobial activities. Dilabazian and Na’was (2019) conducted a study on the antibacterial properties of Artemisia verlotiorum methanol extract against 5 MRSA strains and 13 methicillin-sensitive S. aureus strains (MSSA) using the well agar diffusion assay. They observed that the extract effectively inhibited both groups of S. aureus (MRSA and MSSA). This outcome is likely attributed to methanol’s ability to dissolve a higher quantity of secondary metabolites, which could enhance its antimicrobial potential. In general, Gram-positive bacterial strains were inhibited by all extracts while Gram-negative bacteria were inhibited only by n-hexane and dichloromethane extracts. This result was consistent with other studies, which showed that n-hexane-based plant extracts had higher antibacterial activity compared to the other solvents extract (Hussain et al., 2022). Also, this result is consistent with those of the previous investigations of Mohammed et al. (2021). Ahameethunisa and Hopper (2012) studied the antimicrobial activity of n-hexane extracts of Artemisia parviflora which showed maximum activity against S. aureus, E. coli, and K. pneumoniae. This study demonstrated that K. pneumoniae and E. coli were resistant to AHA ethyl acetate extract. In a previous study, six organic Artemisia nilagirica solvents were tested against 15 phytopathogens and clinically significant standard reference bacterial strains. The results revealed that all the extracts had inhibitory activity against Gram-positive and Gram-negative bacteria, with the exceptions of K. pneumoniae, Enterococcus faecalis, and S. aureus, which showed these bacteria, were resistant to A. nilagirica extracts. In research by Hussain et al. (2022), it was shown that A. rutifolia extracts in methanol, ethyl acetate, and n-hexane are rich in flavonoids and phenols, and that all of the studied extracts effectively inhibited the development of both Gram-positive and Gram-negative bacteria across a broad spectrum. More accurate data on antibacterial activity were obtained by determining the MIC and MBC values in Table 2. Except for the ethyl acetate extract of AHA against S. aureus (9.375 mg/ml), all plant extracts in the current investigation exhibited MBC values about two times more than their equivalent MICs. This suggests that the extract had both bacteriostatic and bactericidal effects at the same dose. According to MIC and MBC values (a very low MIC exhibits strong antibacterial effects), when compared to cefotaxime, methanol, ethylacetate, and n-hexane extracts exhibited a higher antibacterial effect against MRSA (MIC=1.17 ± 1.09 mg/ml, MBC=9.375 ± 0.0 mg/ml), (MIC=2.34 ± 1.36 mg/ml, MBC=4.69 ± 2.7 mg/ml), and (MIC=2.34 ± 1.25 mg/ml, MBC=18.75 ± 2.7 mg/ml), respectively, whereas S. aureus and K. pneumonia were the most resistant with a high MIC and MBC values of AHA by utilizing methanol extract (MIC=37.5 ± 0.0 mg/ml, MBC=75 ± 7.16 mg/ml), (MIC=37.5 ± 0.0 mg/ml, MBC=75 ± 0.0 mg/ml), respectively. These values are quite comparable to those reported by Bertella et al. (2018), using an additional chemotype of AHA essential oils against S. aureus strains (MRSAA1, MRSAB1) with MIC and MBC of 5 and 10 mg/ml, respectively. In our study, the highest antibacterial activity (MIC=1.17 ± 1.09 mg/ml and MBC=9.375 ± 0.0 mg/ml) against MRSA was recorded for methanol extract. The antibacterial activity against MRSA methanol extract, Echeverría et al. (2017), confirmed the substantial antimicrobial activity exhibited by the methanolic extract of Artemisia absinthium, suggesting that the bioactivity of flavones and flavonoids are potential antibacterial agents is responsible for antibacterial activity, also, the same author reported the spectrum of activity of flavones was more against Gram-positive bacteria because of the wide range of lipophilicity and cell lysis. In addition, other investigations of Artemisia species’ in vitro antimicrobial activity have shown findings that are comparable to those of the current study. The methanolic extract of Artemisia campestris and AHA grown in Southern Algeria had a negative inhibitory effect on E. coli and K. pneumonia (Bakchiche et al., 2022). In addition, Mashraqi et al. (2023) reported on negative inhibitory effect on S. aureus by using methanol extract of AHA and A. absinthium. Consequently, n-hexane was more effective against all of the tested bacteria; this may be because the active chemicals are more soluble in hexane, this was also noticed by Abu-Darwish et al. (2015). There have been several researches on the antibacterial and antioxidant properties of Artemisia species across the world and it is thought that these plants produce important secondary metabolites that have therapeutic benefits against illness (Erel et al., 2012; Javid et al., 2015). Hexane extract is a very effective inhibitor for clinical pathogenic bacteria, as shown by the results of the zone of inhibition and MIC investigations (Ahameethunisa and Hopper, 2012). Ahameethunisa and Hopper (2010, 2012) studied the antibacterial activity of different solvent extracts of Artemisia parviflora grown in India (e.g., methanol, ethanol, chloroform, n-hexane, petroleum ether, ethyl acetate, and acetone) showed inhibitory effect against Gram-positive and Gram-negative bacteria. The results revealed that the n-hexane extract of A. parviflora showed a high level of antimicrobial activity for all the microbes tested with the MIC value of 32–64 mg/ml. Methanol and ethyl acetate extracts of A. parviflora showed moderate antimicrobial activity, due to the presence of higher concentrations of active antimicrobial agents such as terpenoids, phenolics, and volatile oils, in Artemisia species (Hussain et al., 2022). It is well-established that the efficacy of plants is linked to their composition of bioactive compounds. Consequently, numerous studies have been conducted on the whole plant of AHA, employing various solvents and essential oils, to explore the presence of these bioactive compounds. One study conducted by Hudaib and Aburjai (2006) reported that the main components of the essential oil from the aerial parts of AHA from Jordan were trans-sabinyl acetate (5.4%), germacrene D (4.6%), α-eudesmol (4.2%), and caryophyllene acetate (5.7%) (Hudaib and Aburjai, 2006). Also, Amkiss et al. (2021) showed that the major phytocomponents identified in AHA ethanolic extract using GC–MS were Anobin (37.30), a- Santonin (36.53), and Alkhanin (36.02). Moreover, another study done by Tilaoui et al. (2011) showed that the major chemical composition of the essential oil of aerial parts of AHA was Bisabolone oxidea (17.55) and Farnesene epoxide, Ea (17.08). They also reported that the major compounds identified in this plant were β-Thujone (25.1), α-Thujone (22.9), and 1,8-Cineole (20.1). In addition, terpenoids are among the most commonly encountered active antimicrobial compounds discovered in plants. Research has demonstrated that terpenoids possess antimicrobial properties against bacteria, including strains that are both susceptible to and resistant to antibiotics. This is mostly due to their capacity to encourage cell rupture and to hinder the production of protein and DNA (Álvarez-Martínez et al., 2021). Continuously searching for new natural anticancer compounds within medicine plants and traditional foods is a promising strategy for discovering a new anticancer agent that is safe and able to overcome the multidrug resistance developed against conventional chemotherapy. Accordingly, the present research assessed the cytotoxic effects of AHA extracts against colorectal carcinoma cell lines (HCT-116). Our results indicate that the different solvent fractions displayed significant inhibitory effects on the growth of HCT-116 cells in a dose-dependent manner. Among the tested extracts, the methanol fraction exhibited the highest cytotoxic effects (IC50=126.61 ± 13.35 μg/ml), followed by ethyl acetate (IC50=259.83 ± 9.55 μg/ml), dichloromethane (IC50=266.07 ± 1.61 μg/ml), and n-hexane extracts (IC50=351.55 ± 8.39 μg/ml). 5-Fluorouracil, an anticancer drug, was utilized as a positive control to evaluate and compare the anticancer efficacy of various extracts. Furthermore, the HUVEC normal cell line affirmed the selectivity of various extracts, as all of them demonstrated no activity against HUVEC at concentrations exceeding 400 μg/ml. Our findings align with those of Khlifi et al. (2013), who reported that methanol extract from AHA caused a reduction in cell viability of various human cancer cell lines, including human bladder carcinoma RT112, human laryngeal carcinoma Hep2, and human myelogenous leukemia K-562. In addition, Mohammed et al. (2019) demonstrated the significant cytotoxic and anti-proliferative effects of AHA methanolic extract on the e human hepatocellular carcinoma (HepG2) cell line. To the best of our knowledge, there is currently no existing study that has conducted a comparative analysis of the anticancer potential of AHA extracts obtained using solvents of varying polarities. The current study findings have revealed noteworthy disparities in the cytotoxic effects of the examined fractions. These differences can be ascribed to the unique bioactive compounds present in each extract, a characteristic that is predominantly influenced by the selection of the extraction solvent (Purnamasari et al., 2019). It is noteworthy that the cytotoxic impact of AHA was enhanced by increasing solvent polarity, suggesting that its active anticancer constituents are polar compounds. In prior studies, an evaluation of the chemical composition of the methanolic extract from AHA revealed that the polar sesquiterpenes, artemisinin, is among its primary constituents (Maggar, 2012). It was recently found that artemisinin has anticancer effects against primary colon cancer (SW480) and lymph node metastatic (SW620) (Otto-Ślusarczyk et al., 2021). Furthermore, the study of (Jakovljević et al., 2020) showed that the chlorogenic acid and quercetin-3-O-glucopyranoside of AHA methanolic extract was the most abundant polyphenolic compounds which are characterized for their anticancer properties (Maiyo et al., 2016). ConclusionThe methanol extract exhibited the most potent effects against MRSA and HCT-116, while the AHA hexane extract demonstrated the most effective antibacterial action against S. aureus. Future research efforts should emphasize on isolating particular chemical constituents from AHA and give priority to assessing their cytotoxic effects on mammalian cells. If certain elements prove to be safe, it would be intriguing to explore their potential therapeutic roles in addressing specific diseases, potentially combining traditional remedies with pharmaceutical treatments. AcknowledgmentsResearchers would like to thank the Deanship of Scientific Research, Imam Mohammad Ibn Saud Islamic University for funding the publication of this project. Conflict of interestThe authors declare that there is no conflict of interest. FundingPublication of this research was funded by the Deanship of Scientific Research, Imam Mohammad Ibn Saud Islamic University, Saudi Arabia. Author contributionsRA, SD, MA, FN, and SS concept and design the proposal. SA, SA, MA, FN, and OA collect the required data. RA, SD, SS, OA, SA, MA, and FN analyzed the collected data and wrote the manuscript. All authors revised and approved the final manuscript. Data availabilityAll data generated and analyzed are included in this research article. ReferencesAanouz, I., Belhassan, A., El-Khatabi, K., Lakhlifi, T., El-Ldrissi, M. and Bouachrine, M. 2021. Moroccan medicinal plants as inhibitors against SARS-CoV-2 main protease: computational investigations. J. Biomol. Struct. Dyn. 39(8), 2971–2979. Abu-Darwish, M., Cabral, C., Gonçalves, M., Cavaleiro, C., Cruz, M., Efferth, T. and Salgueiro, L. 2015. Artemisia herba-alba essential oil from Buseirah (South Jordan): chemical characterization and assessment of safe antifungal and anti-inflammatory doses. J. Ethnopharmacol. 174, 153–160. Adu-Amankwaah, F., Sam, H., Asare, C.Y. and Mills-Robertson, F.C. 2023. Antimicrobial, antioxidant activities, and total phenolic contents of Pycnanthus angolensis Sap and Cryptolepis sanguinolenta root extracts. BMC Complement Altern. Med. 23(1), 1–12. Ahameethunisa, A.R. and Hopper, W. 2010. Antibacterial activity of Artemisia nilagirica leaf extracts against clinical and phytopathogenic bacteria. BMC Complement Altern. Med. 10(1), 1–6. Ahameethunisa, A.R. and Hopper, W. 2012. In vitro antimicrobial activity on clinical microbial strains and antioxidant properties of Artemisia parviflora. Ann. Clin. Microbiol. Antimicrob. 11(1), 1–7. Al-Qura’n, S. 2009. Ethnopharmacological survey of wild medicinal plants in Showbak, Jordan. J. Ethnopharmacol. 123(1), 45–50. Álvarez-Martínez, F., Barrajón-Catalán, E., Herranz-López, M. and Micol, V. 2021. Antibacterial plant compounds, extracts and essential oils: an updated review on their effects and putative mechanisms of action. Phytomedicine 90, 153626. Amkiss, S., Dalouh, A. and Idaomar, M. 2021. Chemical composition, genotoxicity and antigenotoxicity study of Artemisia herba-alba using the eye and wing SMART assay of Drosophila melanogaster. Arabian J. Chem. 14(3), 102976. Bakchiche, B., Gören, A.C., Aydoğmuş, Z., Mataracikara, E. and Ghareeb, M.A. 2022. Artemisia campestris and Artemisia herbaalba: LC-HRESI-MS profile alongside their antioxidant and antimicrobial evaluation. Acta Pharm. Sci. 60(2), 131–152. Basheti, I.A., Elayeh, E.R., DB, D.B. and el Hait, S.S. 2017. Opinions of pharmacists and herbalists on herbal medicine use and receiving herbal medicine education in Jordan. Trop. J. Pharm. Res. 16(3), 689–696. Bauer, A., Kirby, W., Sherris, J.C. and Turck, M. 1966. Antibiotic susceptibility testing by a standardized single disk method. Am. J. Clin. Pathol. 45(4), 493–496. Benmeziane, S., Haddadin, M.S. and Al-Domi, H.A. 2023. Extraction yield, phytochemicals analysis, and certain in vitro biological activities of Artemisia herba alba extracts. Jordan J. Biol. Sci. 19(2), 125–141. Bertella, A., Benlahcen, K., Abouamama, S., Pinto, D.C., Maamar, K., Kihal, M. and Silva, A.M. 2018. Artemisia herba-alba Asso. essential oil antibacterial activity and acute toxicity. Ind. Crops. Prod. 116, 137–143. Boukraa, N., Ladjel, S., Benlamoudi, W., Goudjil, M.B., Berrekbia, M. and Eddoud, A. 2022. Insecticidal and repellent activities of Artemisia herba alba Asso, Juniperus phoenicea L and Rosmarinus officinalis L essential oils in synergized combinations against adults of Tribolium castaneum (Herbst) (Coleoptera: Tenebrionidae). Biocatal. Agric. Biotechnol. 45, 102513. Bourebaba, Y., Mularczyk, M., Kornicka-Garbowska, K., Marycz, K., Bourebaba, L. and Kowalczuk, A. 2023. Ethanolic extract of artemisia herba-alba ameliorates hyperinsulinemia and hyperglycemia-induced hepg2 cells through cell survival promotion, oxidative stress mitigation, and insulin signaling restoration. Curr. Bioact. Compd. 19(6), 77–93. Caneiras, C., Lito, L., Melo-Cristino, J. and Duarte, A. 2019. Community-and hospital-acquired Klebsiella pneumoniae urinary tract infections in Portugal: virulence and antibiotic resistance. Microorganisms 7(5), 138. Dadgostar, P. 2019. Antimicrobial resistance: implications and costs. Infect Drug Resist. 12, 3903. Daoudi, W., Bouhout, B., Azzouzi, M., Mansour, I. and Oussaid, A. 2022. Biological activity of leaves and stems extracts of Artemisia herba-alba from the Oriental region of Morocco and extraction of Cellulose from this plant (isolation, modification and applications). Moroc. J. Chem. 10(4), 10–14. Davis, M.E., Liu, T.-L., Taylor, Y.J., Davidson, L., Schmid, M., Yates, T. and Spencer, M.D. 2017. Exploring patient awareness and perceptions of the appropriate use of antibiotics: a mixed-methods study. Antibiotics 6(4), 23. Dif, M.M. and Fatima Zohra, D. 2023. Antimicrobial properties and physical characteristics of essential oil extracted from Artemisia herba alba collected in El Bayadh, Algeria. bioRxiv 2023, 536798. Dilabazian, H. and Na’was, T. 2019. Methanol extract of Artemisia verlotiorum: an effective inhibitor of Staphylococcus aureus clinical isolates. IOSR J. Pharm. 9(4), 5–9. Dixit, A., Kumar, N., Kumar, S. and Trigun, V. 2019. Antimicrobial resistance: progress in the decade since emergence of New Delhi metallo-β-lactamase in India. Indian J. Community Med. 44(1), 4. Echeverría, J., Opazo, J., Mendoza, L., Urzúa, A. and Wilkens, M. 2017. Structure-activity and lipophilicity relationships of selected antibacterial natural flavones and flavanones of Chilean flora. Molecules 22(4), 608. El-Dahiyat, F., Rashrash, M., Abuhamdah, S., Abu Farha, R. and Babar, Z.-U.-D. 2020. Herbal medicines: a cross-sectional study to evaluate the prevalence and predictors of use among Jordanian adults. J. Pharm. Policy Pract. 13, 1–9. Elsonbaty, S.M., Eltahawy, N., Al-dmour, S.M., Easa, S. and Qaralleh, H. 2020. Ionizing radiation effect on Teucrium polium: phytochemical contents antioxidant and antibacterial activity. Arab. J. Nucl. Sci. Appl. 53(2), 98–110. Erel, Ş.B., Reznicek, G., Şenol, S.G., Yavaşoğlu, N.Ü.K., Konyalioğlu, S. and Zeybek, A.U. 2012. Antimicrobial and antioxidant properties of Artemisia L. species from western Anatolia. Turk. J. Biol. 36(1), 75–84. Harding, C.M., Hennon, S.W. and Feldman, M.F. 2018. Uncovering the mechanisms of Acinetobacter baumannii virulence. Nat. Rev. Microbiol. 16(2), 91–102. Huang, L., Huang, C., Yan, Y., Sun, L. and Li, H. 2022. Urinary tract infection etiological profiles and antibiotic resistance patterns varied among different age categories: a retrospective study from a tertiary general hospital during a 12-year period. Front. Microbiol. 12, 813145. Hudaib, M. and Aburjai, T. 2006. Composition of the essential oil from Artemisia herba-alba grown in Jordan. J. Essent. Oil Res. 18, 301–304. Hussain, A., Sajid, M., Rasheed, H., Hassan, M., Khan, M.A. and Bokhari, S.A.I. 2022. Phytochemistry and antibacterial efficacy of Northeastern Pakistani Artemisia rutifolia Stephan ex Spreng. extracts against some clinical and phyto-pathogenic bacterial strains. Acta Pharm. Sci. 60(3), 247–271. Hwang, W. and Yoon, S.S. 2019. Virulence characteristics and an action mode of antibiotic resistance in multidrug-resistant Pseudomonas aeruginosa. Sci. Rep. 9(1), 1–15. Jakovljević, M.R., Grujičić, D., Vukajlović, J.T., Marković, A., Milutinović, M., Stanković, M. and Milošević-Djordjević, O. 2020. In vitro study of genotoxic and cytotoxic activities of methanol extracts of Artemisia vulgaris L. and Artemisia alba Turra. S. Afr. J. Bot. 132, 117–126. Javid, T., Adnan, M., Tariq, A., Akhtar, B., Ullah, R. and Abd El Salam, N.M. 2015. Antimicrobial activity of three medicinal plants (Artemisia indica, Medicago falcate and Tecoma stans). Afr. J. Tradit. Complement Altern. Med. 12(3), 91–96. Jouad, H., Haloui, M., Rhiouani, H., El Hilaly, J. and Eddouks, M. 2001. Ethnobotanical survey of medicinal plants used for the treatment of diabetes, cardiac and renal diseases in the North centre region of Morocco (Fez–Boulemane). J. Ethnopharmacol. 77(2-3), 175–182. Kaçar, D., Bayraktar, O., Erdem, C., Alamri, A.S. and Galanakis, C.M. 2022. Antioxidant and antimicrobial activities of plants grown in the Mediterranean region. JSFA Rep. 2(9), 452–461. Kebede, T., Gadisa, E. and Tufa, A. 2021. Antimicrobial activities evaluation and phytochemical screening of some selected medicinal plants: A possible alternative in the treatment of multidrug-resistant microbes. PLoS One 16(3), e0249253. Khan, M., Khan, M., Al-Hamoud, K., Adil, S.F., Shaik, M.R. and Alkhathlan, H.Z. 2022. Comprehensive phytochemical analysis of various solvent extracts of Artemisia judaica and their potential anticancer and antimicrobial activities. Life 12(11), 1885. Khlifi, D., Sghaier, R.M., Amouri, S., Laouini, D., Hamdi, M. and Bouajila, J. 2013. Composition and anti-oxidant, anti-cancer and anti-inflammatory activities of Artemisia herba-alba, Ruta chalpensis L. and Peganum harmala L. Food Chem. Toxicol. 55, 202–208. Laid, M., Hegazy, M.E.F., Ahmed, A.A., Ali, K., Belkacemi, D. and Ohta, S. 2008. Sesquiterpene lactones from Algerian Artemisia herba-alba. Phytochem. Lett. 1(2), 85–88. Lasko, M.J. and Nicolau, D.P. 2020. Carbapenem-resistant Enterobacterales: considerations for treatment in the era of new antimicrobials and evolving enzymology. Curr. Infect. Dis. Rep. 22, 1–12. Maggar, E.M.B.E. 2012. Artemisia herba alba & Artemisia monosperma: the discovery of the first potential Egyptian plant sources for the pharmaceutical commercial production of artemisinin and some of its related analogues. J. Appl. Pharm. Sci. 2(7), 77–91. Maiyo, C.F., Moodley, R. and Singh, M. 2016. Cytotoxicity, antioxidant and apoptosis studies of quercetin-3-O glucoside and 4-(β-D-glucopyranosyl-1→ 4-α-L-rhamnopyranosyloxy)-benzyl isothiocyanate from Moringa oleifera. Anticancer Agents Med. Chem. 16(5), 648–656. Mashraqi, A., Al Abboud, M.A., Ismail, K.S., Modafer, Y., Sharma, M. and El-Shabasy, A. 2023. Correlation between antibacterial activity of two Artemisia sp. extracts and their plant characteristics. bioRxiv 2023, 542989. Mbuni, Y.M., Wang, S., Mwangi, B.N., Mbari, N.J., Musili, P.M., Walter, N.O. and Wang, Q. 2020. Medicinal plants and their traditional uses in local communities around Cherangani Hills, Western Kenya. Plants 9(3), 331. Mohammed, H.Y., Alsenosy, N.K., Ebeed, N. and Fahmy, K.I.E. 2019. Estimation of anticancer effect of methanolic extract of Artemisia herba alba on human cancer cell lines. Arab. Univ. J. Agric. Sci. 27(4), 2215–2222. Mohammed, M.J., Anand, U., Altemimi, A.B., Tripathi, V., Guo, Y. and Pratap-Singh, A. 2021. Phenolic composition, antioxidant capacity and antibacterial activity of white wormwood (Artemisia herba-alba). Plants 10(1), 164. Mosmann, T. 1983. Rapid colorimetric assay for cellular growth and survival: application to proliferation and cytotoxicity assays. J. Immunol. Methods 65(1-2), 55–63. Moufid, A. and Eddouks, M. 2012. Artemisia herba alba: a popular plant with potential medicinal properties. Pak. J. Biol. Sci. 15(24), 1152–1159. Murray, C.J., Ikuta, K.S., Sharara, F., Swetschinski, L., Aguilar, G.R., Gray, A. and Wool, E. 2022. Global burden of bacterial antimicrobial resistance in 2019: a systematic analysis. Lancet 399, 629–655. Mushore, J. and Matuvhunye, M. 2013. Antibacterial properties of Mangifera indica on Staphylococcus aureus. Afr. J. Clin. Exp. Microbiol. 14(2), 62–74. Nikolić, M. and Stevović, S. 2015. Family Asteraceae as a sustainable planning tool in phytoremediation and its relevance in urban areas. Urban For. Urban Green. 14(4), 782–789. Otto-Ślusarczyk, D., Mielczarek-Puta, M. and Graboń, W. 2021. The real cytotoxic effect of artemisinins on colon cancer cells in a physiological cell culture setting. How composition of the culture medium biases experimental findings. Pharmaceuticals 14(10), 976. Ouchelli, Y., Dahmani, N., Addi, Y., Hechiche, N. and Baaliouamer, A. 2022. Chemical characterization of volatile extract of Artemisia herba-alba and study of its antioxidant, antimicrobial and antifungal activities and its inhibitionory effect on corrosion of aluminum in hydrogen chloride solution. J. Microbiol. Biotechnol. Food Sci. 11(4), e4889–e4889. Ogbiko, C., Eboka, C.J. and Tambuwal, A.D. 2018. Extraction and fractionation of whole black seed plantain (Plantago rugelii Decne) for in-vitro antioxidant, antibacterial and phytochemical screening. J. Appl. Sci. Environ. Manag. 22(5), 613–618. Ouguirti, N., Bahri, F., Bouyahyaoui, A. and Wanner, J. 2021. Chemical characterization and bioactivities assessment of Artemisia herba-alba Asso essential oil from South-western Algeria. Nat. Vol. Essent. Oil. 8(2), 27–36. Purnamasari, R., Winarni, D., Permanasari, A.A., Agustina, E., Hayaza, S. and Darmanto, W. 2019. Anticancer activity of methanol extract of Ficus carica leaves and fruits against proliferation, apoptosis, and necrosis in Huh7it cells. Cancer Inform. 18, 1176935119842576. Seo, J., Lee, S., Elam, M.L., Johnson, S.A., Kang, J. and Arjmandi, B.H. 2014. Study to find the best extraction solvent for use with guava leaves (Psidium guajava L.) for high antioxidant efficacy. Food Sci. Nutr. 2(2), 174–180. Thorpe, K.E., Joski, P. and Johnston, K.J. 2018. Antibiotic-resistant infection treatment costs have doubled since 2002, now exceeding $2 billion annually. Health Aff. 37(4), 662–669. Tilaoui, M., Mouse, H.A., Jaafari, A., Aboufatima, R., Chait, A. and Zyad, A. 2011. Chemical composition and antiproliferative activity of essential oil from aerial parts of a medicinal herb Artemisia herba-alba. Rev. Bras. Farmacogn. 21, 781–785. Wazaify, M., Afifi, F.U., El-Khateeb, M. and Ajlouni, K. 2011. Complementary and alternative medicine use among Jordanian patients with diabetes. Complement Ther. Clin. Pract. 17(2), 71–75. Živković, J., Ilić, M., Šavikin, K., Zdunić, G., Ilić, A. and Stojković, D. 2020. Traditional use of medicinal plants in South-Eastern Serbia (Pčinja District): ethnopharmacological investigation on the current status and comparison with half a century old data. Front. Pharmacol. 11, 1020. | ||
| How to Cite this Article |
| Pubmed Style Alghonmeen RD, Dmour SM, Saghir SA, Abushattal S, Alnaimat S, Al-zharani M, Nasr FA, Althunibat OY. Anti-MRSA and cytotoxic activities of different solvent extracts from Artemisia herba-alba grown in Shubak, Jordan. Open Vet. J.. 2024; 14(4): 990-1001. doi:10.5455/OVJ.2024.v14.i4.6 Web Style Alghonmeen RD, Dmour SM, Saghir SA, Abushattal S, Alnaimat S, Al-zharani M, Nasr FA, Althunibat OY. Anti-MRSA and cytotoxic activities of different solvent extracts from Artemisia herba-alba grown in Shubak, Jordan. https://www.openveterinaryjournal.com/?mno=177315 [Access: June 22, 2026]. doi:10.5455/OVJ.2024.v14.i4.6 AMA (American Medical Association) Style Alghonmeen RD, Dmour SM, Saghir SA, Abushattal S, Alnaimat S, Al-zharani M, Nasr FA, Althunibat OY. Anti-MRSA and cytotoxic activities of different solvent extracts from Artemisia herba-alba grown in Shubak, Jordan. Open Vet. J.. 2024; 14(4): 990-1001. doi:10.5455/OVJ.2024.v14.i4.6 Vancouver/ICMJE Style Alghonmeen RD, Dmour SM, Saghir SA, Abushattal S, Alnaimat S, Al-zharani M, Nasr FA, Althunibat OY. Anti-MRSA and cytotoxic activities of different solvent extracts from Artemisia herba-alba grown in Shubak, Jordan. Open Vet. J.. (2024), [cited June 22, 2026]; 14(4): 990-1001. doi:10.5455/OVJ.2024.v14.i4.6 Harvard Style Alghonmeen, R. D., Dmour, . S. M., Saghir, . S. A., Abushattal, . S., Alnaimat, . S., Al-zharani, . M., Nasr, . F. A. & Althunibat, . O. Y. (2024) Anti-MRSA and cytotoxic activities of different solvent extracts from Artemisia herba-alba grown in Shubak, Jordan. Open Vet. J., 14 (4), 990-1001. doi:10.5455/OVJ.2024.v14.i4.6 Turabian Style Alghonmeen, Reham D., Saif M. Dmour, Sultan A.m. Saghir, Saqr Abushattal, Sulaiman Alnaimat, Mohammed Al-zharani, Fahd A. Nasr, and Osama Y. Althunibat. 2024. Anti-MRSA and cytotoxic activities of different solvent extracts from Artemisia herba-alba grown in Shubak, Jordan. Open Veterinary Journal, 14 (4), 990-1001. doi:10.5455/OVJ.2024.v14.i4.6 Chicago Style Alghonmeen, Reham D., Saif M. Dmour, Sultan A.m. Saghir, Saqr Abushattal, Sulaiman Alnaimat, Mohammed Al-zharani, Fahd A. Nasr, and Osama Y. Althunibat. "Anti-MRSA and cytotoxic activities of different solvent extracts from Artemisia herba-alba grown in Shubak, Jordan." Open Veterinary Journal 14 (2024), 990-1001. doi:10.5455/OVJ.2024.v14.i4.6 MLA (The Modern Language Association) Style Alghonmeen, Reham D., Saif M. Dmour, Sultan A.m. Saghir, Saqr Abushattal, Sulaiman Alnaimat, Mohammed Al-zharani, Fahd A. Nasr, and Osama Y. Althunibat. "Anti-MRSA and cytotoxic activities of different solvent extracts from Artemisia herba-alba grown in Shubak, Jordan." Open Veterinary Journal 14.4 (2024), 990-1001. Print. doi:10.5455/OVJ.2024.v14.i4.6 APA (American Psychological Association) Style Alghonmeen, R. D., Dmour, . S. M., Saghir, . S. A., Abushattal, . S., Alnaimat, . S., Al-zharani, . M., Nasr, . F. A. & Althunibat, . O. Y. (2024) Anti-MRSA and cytotoxic activities of different solvent extracts from Artemisia herba-alba grown in Shubak, Jordan. Open Veterinary Journal, 14 (4), 990-1001. doi:10.5455/OVJ.2024.v14.i4.6 |